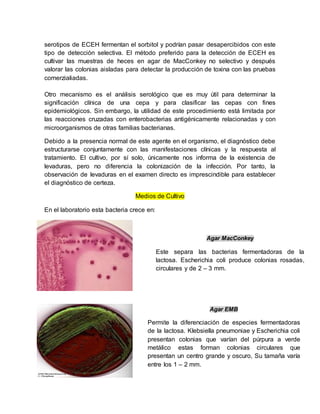
serotipos de ECEH fermentan el sorbitol y podrían pasar desapercibidos con este
tipo de detección selectiva. El método preferido para la detección de ECEH es
cultivar las muestras de heces en agar de MacConkey no selectivo y después
valorar las colonias aisladas para detectar la producción de toxina con las pruebas
comerzialiadas.
Otro mecanismo es el análisis serológico que es muy útil para determinar la
significación clínica de una cepa y para clasificar las cepas con fines
epidemiológicos. Sin embargo, la utilidad de este procedimiento está limitada por
las reacciones cruzadas con enterobacterias antigénicamente relacionadas y con
microorganismos de otras familias bacterianas.
Debido a la presencia normal de este agente en el organismo, el diagnóstico debe
estructurarse conjuntamente con las manifestaciones clínicas y la respuesta al
tratamiento. El cultivo, por sí solo, únicamente nos informa de la existencia de
levaduras, pero no diferencia la colonización de la infección. Por tanto, la
observación de levaduras en el examen directo es imprescindible para establecer
el diagnóstico de certeza.
Medios de Cultivo
En el laboratorio esta bacteria crece en:
Agar MacConkey
Este separa las bacterias fermentadoras de la
lactosa. Escherichia coli produce colonias rosadas,
circulares y de 2 – 3 mm.
Agar EMB
Permite la diferenciación de especies fermentadoras
de la lactosa. Klebsiella pneumoniae y Escherichia coli
presentan colonias que varían del púrpura a verde
metálico estas forman colonias circulares que
presentan un centro grande y oscuro, Su tamaña varía
entre los 1 – 2 mm.
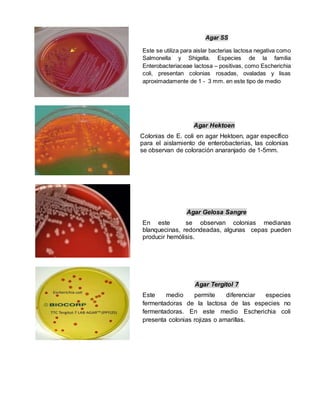
Agar SS
Este se utiliza para aislar bacterias lactosa negativa como
Salmonella y Shigella. Especies de la familia
Enterobacteriaceae lactosa – positivas, como Escherichia
coli, presentan colonias rosadas, ovaladas y lisas
aproximadamente de 1 - 3 mm. en este tipo de medio
Agar Hektoen
Colonias de E. coli en agar Hektoen, agar específico
para el aislamiento de enterobacterias, las colonias
se observan de coloración anaranjado de 1-5mm.
Agar Gelosa Sangre
En este se observan colonias medianas
blanquecinas, redondeadas, algunas cepas pueden
producir hemólisis.
Agar Tergitol 7
Este medio permite diferenciar especies
fermentadoras de la lactosa de las especies no
fermentadoras. En este medio Escherichia coli
presenta colonias rojizas o amarillas.

El documento proporciona una descripción detallada de Escherichia coli, un microorganismo relevante en la salud humana, capaz de causar diversas enfermedades como la gastroenteritis y infecciones urinarias. Se clasifica en diferentes cepas patógenas, cada una con características y mecanismos de virulencia específicos, que son responsables de una variedad de manifestaciones clínicas. Además, se destaca su importancia como comensal en el intestino humano y su potencial patogénico en condiciones de alteración del sistema inmune.



![salvo por la aparición de brotes pero frecuentes en guarderías y la enfermedad es
poco frecuente en niños mayores y adultos, porque se han desarrollado una
inmunidad protectora. Estas presentan la capacidad de adherirse a células HEp-2
(línea celular de carcinoma faríngeo humana) formando microcolonias. Este patrón
fue denominado posteriormente como adherencia localizada. Una vez formadas
las microcolonias comienza una segunda fase de adherencia, con la destrucción
de las microvellosidades intestinales, proceso al que se ha denominado como
esfacelamiento. La falta de microvellosidades permite a las bacterias adherirse en
forma íntima a receptores de la membrana presentes en la célula epitelial.
Factores de virulencia
La infección se caracteriza por la adhesión bacteriana a las células epiteliales del
intestino delgado con la destrucción posterior de las microvellosidades
(histopatología por unión/borrado [U/B]). La agregación inicial de las bacterias que
determina la formación de microcolonias en la superficie de las células epiteliales
viene mediada por los Pili formadores de haces (BFP) codificados por plásmidos.
Los estudios posteriores del anclaje vienen regulados por los genes codificados
por plásmidos. Los estadios posteriores vienen regulados por los genes
codificados en el islote de patogenicidad. Este islote de más de 40 genes es
responsable de la unión a la superficie de la célula anfitriona y su destrucción.
Tras la unión laxa mediada por los BFP, se produce una secreción activa de
proteínas hacia el interior de la célula anfitriona epitelial por el sistema de
secreción de tipo III. Una proteína, el receptor de la intimina translocada (Tir), se
inserta en la membrana epitelial y actúa como receptor de una adhesina
bacteriana de la membrana externa, la intimina. La unión de la intimia con Tir
determina la polimerizaron de la actina y la acumulación de elementos del
citoesqueleto por debajo de las bacterias ancladas, con pérdida de la integridad de
la superficie celular y muerte de la célula
Cuadro clínico
Es caracterizada por la lesión histopatológica de la superficie apical de los
enterocitos, conocida como "Adherencia y y Esfascelamiento" (A/E).
Afecta la mucosa intestinal al conducir a la disolución del borde en cepillo
por vesiculación de las microvellosidades, con pérdida de disacaridasas, lo
que a su vez altera la absorción y conduce a la producción de una diarrea
secretora, que puede estar asociada a fiebre.](https://image.slidesharecdn.com/resumen-151122190642-lva1-app6892/85/Resumen-escherichia-coli-4-320.jpg)